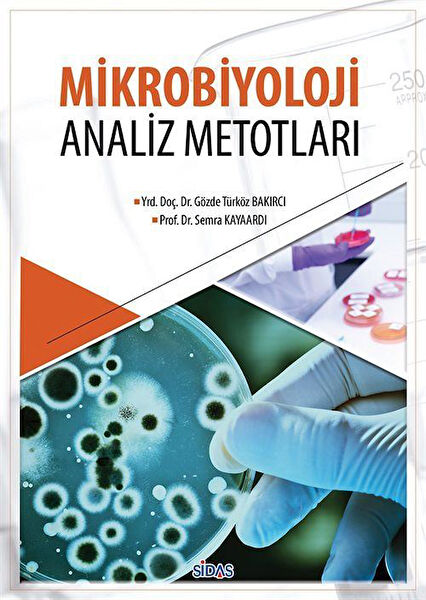
Sidas Yayınları Bilim ve Teknik

-
Anasayfa
-
Kitap, Kırtasiye, Hobi, Oyuncak
-
Kitap
-
Bilim ve Teknik Kitapları
- Sidas Yayınları Bilim ve Teknik Kitapları
Mikrobiyoloji Analiz Metotları / Dr. Gözde Türköz Bakırcı
Sidas Yayınları

Tüm Ürün Açıklamasını Gör
483,39 TL
Sepette
459,23 TL